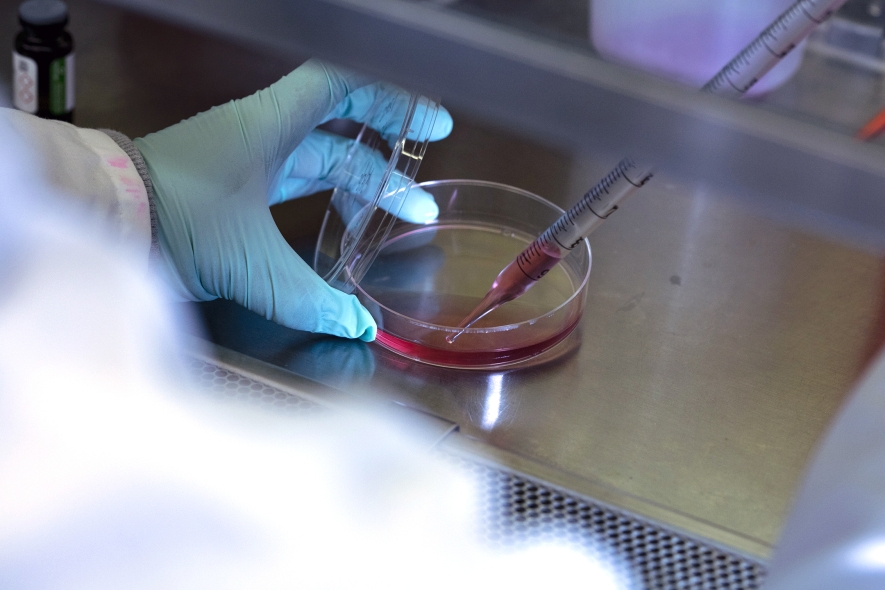

The Surgical Cardiovascular Research Institute (CVRI) at Columbia fosters bold, impactful research across basic, translational, and clinical science to advance the field of cardiovascular surgery and support the outstanding research community at Columbia University Irving Medical Center.

About the Surgical CVRI
Our vision at the Surgical CVRI is to advance knowledge and understanding of cardiovascular disease processes, developing new surgical therapies and technology that will improve patient care and outcomes.

Our mission is to provide organizational structure and funding mechanisms to conduct cutting-edge basic, translational, and clinical science research in the broad field of cardiovascular diseases. The Surgical CVRI includes the country's brightest scientists, surgeons, physicians, engineers, trainees and students, all working together to advance the field of cardiovascular research and surgery.
Our Research
The Surgical CVRI is home to groundbreaking research across many different areas of cardiovascular medicine, including:
- Heart transplantation and immunology
- Implantable biomaterials and medical devices
- Small and large animal surgical models for cardiovascular conditions
- Heart valve and aortic diseases
- Congenital heart defects
Highlights of the CVRI
- Our CVRI members initiated the first multi-center study on valve transplant
- We developed the first congenital robotic cardiac program, with the youngest worldwide pediatric robotic cardiac surgery.
- We established a CVRI Biobank as a centralized resources across the NYP/Columbia enterprise.
- Members of the CVRI have multiple active awards as Principal Investigator from the National Institutes of Health [R01 HL 155381 (Kalfa D), R01 HL179224 (Kalfa D), R01 HL170573 (Ferrari G), R01 HL 163085 and HL 163085 S1 (Ferrari G), R01 HL 131872 and R01 HL 131872 S1 (Ferrari G), the American Association for Thoracic Surgery (Goldstone A), and the American Heart Association (Goldstone A), among numerous other industry-sponsored grants and awards.
- Our faculty have presented at and served in leadership positions in multiple major national and international meetings related to cardiac surgery and cardiology, including: American Association for Thoracic Surgery, Society of Thoracic Surgeon, American Heart Association, American College of Cardiology, Transcatheter Cardiovascular Therapeutic, New York Valves, Technology and Heart Failure Therapeutics, European Association of Cardio-Thoracic Surgery, International Society for Heart and Lung Transplantation, International Society for Minimally Invasive Cardiothoracic Surgery, NeoHeart, Congenital Heart Surgeons Society, International Society of Applied Cardiovascular Biology.
- We have established multiple original, successful educational activities for cardiac professionals around the world, including our Annual Cardiovascular Summit, Practical Approaches to Managing Cardiovascular Disease: Case Based Learning event, the Columbia Transplant Initiative (CTI) and The Department of Surgery Research Symposium
Stories & Perspectives
Columbia Surgical Cardiovascular Research Institute (CVRI) Aims to Advance the Field of Cardiovascular Surgery
Learn how Columbia Surgical Cardiovascular Research Institute serves as resource and support system for researchers and physician-scientists across Columbia.
Research Labs
The Surgical CVRI serves as a point of connection for a number of NIH-funded laboratories and research, encouraging and facilitating collaboration.
- Ferrari Lab
- Pediatric Heart Valve Lab
- Goldstone Lab
- Geirsson Lab
- Cardiac Surgery Outcome Research Lab
Clinical Trials
Learn more from our Clinical Research Core
Stories & Perspectives
Removing Obstacles to Cardiac Surgery Research: A Conversation with Giovanni Ferrari, MD
Learn how Columbia’s Surgical CVRI supports cutting-edge cardiac surgery research, biobanking, AI, and innovation in organ preservation and device development.
Selected Publications
Our members are shaping tomorrow’s research with a deep and highly cited body of publications covering all areas of cardiovascular care.
- Gaudino M, Benedetto U, Bakaeen F, Rahouma M, Tam DY, Abouarab A, Di Franco A, Leonard J, Elmously A, Puskas JD, Angelini GD, Girardi LN, Fremes SE, Taggart DP. Off- Versus On-Pump Coronary Surgery and the Effect of Follow-Up Length and Surgeons' Experience: A Meta-Analysis. J Am Heart Assoc. 2018 Nov 6;7(21):e010034. doi: 10.1161/JAHA.118.010034. PMID: 30373421; PMCID: PMC6404195.
- Salemi A, Sedrakyan A, Mao J, Elmously A, Wijeysundera H, Tam DY, Di Franco A, Redwood S, Girardi LN, Fremes SE, Gaudino M. Individual Operator Experience and Outcomes in Transcatheter Aortic Valve Replacement. JACC Cardiovasc Interv. 2019 Jan 14;12(1):90-97. doi: 10.1016/j.jcin.2018.10.030. Epub 2018 Dec 12. PMID: 30553706.
- Elmously A, Gray KD, Michelassi F, Afaneh C, Kluger MD, Salemi A, Watkins AC, Pomp A. Operating Room Attire Policy and Healthcare Cost: Favoring Evidence over Action for Prevention of Surgical Site Infections. J Am Coll Surg. 2019 Jan;228(1):98-106. doi: 10.1016/j.jamcollsurg.2018.06.010. Epub 2018 Oct 22. PMID: 30359824.
- Rahouma M, Arisha MJ, Elmously A, El-Sayed Ahmed MM, Spadaccio C, Mehta K, Baudo M, Kamel M, Mansor E, Ruan Y, Morsi M, Shmushkevich S, Eldessouki I, Rahouma M, Mohamed A, Gambardella I, Girardi L, Gaudino M. Cardiac tumors prevalence and mortality: A systematic review and meta-analysis. Int J Surg. 2020 Apr;76:178-189. doi: 10.1016/j.ijsu.2020.02.039. Epub 2020 Mar 10. PMID: 32169566.
- Waldron C, Mori M, Krane M, Reinhardt SW, Ahmad Y, Kaple R, Forrest JK, Geirsson A. Implementing Formal Mitral Heart Team Improves Multidisciplinary Evaluation Rate and Survival of Patients With Severe Primary Mitral Regurgitation. J Am Heart Assoc. 2024 May 7;13(9):e033324. doi: 10.1161/JAHA.123.033324. Epub 2024 Feb 23. PMID: 38390804; PMCID: PMC11179864.
- Mori M, Parsons N, Krane M, Guy TS, Grossi EA, Dearani JA, Habib RH, Badhwar V, Geirsson A. Robotic Mitral Valve Repair for Degenerative Mitral Regurgitation. Ann Thorac Surg. 2024 Jan;117(1):96-104. doi: 10.1016/j.athoracsur.2023.07.047. Epub 2023 Aug 16. PMID: 37595861.
- Schroder JN, Patel CB, DeVore AD, Bryner BS, Casalinova S, Shah A, Smith JW, Fiedler AG, Daneshmand M, Silvestry S, Geirsson A, Pretorius V, Joyce DL, Um JY, Esmailian F, Takeda K, Mudy K, Shudo Y, Salerno CT, Pham SM, Goldstein DJ, Philpott J, Dunning J, Lozonschi L, Couper GS, Mallidi HR, Givertz MM, Pham DT, Shaffer AW, Kai M, Quader MA, Absi T, Attia TS, Shukrallah B, Sun BC, Farr M, Mehra MR, Madsen JC, Milano CA, D'Alessandro DA. Transplantation Outcomes with Donor Hearts after Circulatory Death. N Engl J Med. 2023 Jun 8;388(23):2121-2131. doi: 10.1056/NEJMoa2212438. PMID: 37285526.
- Li X, Jiang Q, Song G, Barkestani MN, Wang Q, Wang S, Fan M, Fang C, Jiang B, Johnson J, Geirsson A, Tellides G, Pober JS, Jane-Wit D. A ZFYVE21-Rubicon-RNF34 signaling complex promotes endosome-associated inflammasome activity in endothelial cells. Nat Commun. 2023 May 24;14(1):3002. doi: 10.1038/s41467-023-38684-2. Erratum in: Nat Commun. 2023 Jun 7;14(1):3336. doi: 10.1038/s41467-023-39154-5. Erratum in: Nat Commun. 2023 Dec 18;14(1):8404. doi: 10.1038/s41467-023-44225-8. PMID: 37225719; PMCID: PMC10209169.
- Gammie JS, Chu MWA, Falk V, Overbey JR, Moskowitz AJ, Gillinov M, Mack MJ, Voisine P, Krane M, Yerokun B, Bowdish ME, Conradi L, Bolling SF, Miller MA, Taddei-Peters WC, Jeffries NO, Parides MK, Weisel R, Jessup M, Rose EA, Mullen JC, Raymond S, Moquete EG, O'Sullivan K, Marks ME, Iribarne A, Beyersdorf F, Borger MA, Geirsson A, Bagiella E, Hung J, Gelijns AC, O'Gara PT, Ailawadi G; CTSN Investigators. Concomitant Tricuspid Repair in Patients with Degenerative Mitral Regurgitation. N Engl J Med. 2022 Jan 27;386(4):327-339. doi: 10.1056/NEJMoa2115961. Epub 2021 Nov 13. PMID: 34767705; PMCID: PMC8796794.
- Levine D, Patel P, Zhao Y, Childress P, Chung M, Leshnower BG, Kurlansky P, Smith CR, Chen EP, Takayama H. Bicuspid aortic valve durability with valve-sparing aortic root replacement: comparison to tricuspid valve. Eur J Cardiothorac Surg. 2023 Apr 3;63(4):ezad030. doi: 10.1093/ejcts/ezad030. PMID: 36702459
- Rajesh K, Chung M, Levine D, Norton E, Patel P, Childress P, Zhao Y, Wang P, Leshnower B, Kurlansky P, Chen E, Takayama H. Long-term outcomes after aortic root replacement for bicuspid aortic valve-associated aneurysm. J Thorac Cardiovasc Surg. 2024 Apr 5:S0022-5223(24)00204-6. doi: 10.1016/j.jtcvs.2024.03.003. PMID: 38691070
- Hayashi H, Itatani K, Akiyama K, Zhao Y, Kurlansky P, DeRoo S, Sanchez J, Ferrari G, Yuzefpolskaya M, Colombo PC, Takeda K, Wu IY, Kainuma A, Takayama H. Influence of aneurysmal aortic root geometry on mechanical stress to the aortic valve leaflet. Eur Heart J Cardiovasc Imaging. 2021 Feb 21:jeab006. doi: 10.1093/ehjci/jeab006. PMID: 33611382
- Kobsa S, Akiyama K, Nemeth SK, Kurlansky PA, Naka Y, Takeda K, Itatani K, Werth EG, Brown LM, Ferrari G, Takayama H. Correlation between aortic valve protein levels and vector flow mapping of wall shear stress and oscillatory shear index in patients supported with continuous-flow left ventricular assist devices. J Heart Lung Transplant. 2023 Jan;42(1):64-75. PMID: 36400676
- Hayashi H, Singh SK, Hahn RT, Akita K, Kurlansky P, Sun J, Vedula V, Leb JS, Shimada YJ, Weiner SD, Takayama H. Mitral regurgitation mechanisms related to systolic anterior motion in hypertrophic cardiomyopathy. J Thorac Dis. 2024 Jan 30;16(1):26-39. doi: 10.21037/jtd-23-1206. Epub 2024 Jan 4. PMID: 38410607
- Chen S, Pop A, Prasad Dasi L, George I. Lifetime Management for Aortic Stenosis: Strategy and Decision-Making in the Current Era. Ann Thorac Surg. 2024 Aug 28:S0003-4975(24)00690-8. doi: 10.1016/j.athoracsur.2024.05.047. Epub ahead of print. PMID: 39214440.
- Guerrero ME, Grayburn P, Smith RL 2nd, Sorajja P, Wang DD, Ahmad Y, Blusztein D, Cavalcante J, Tang GHL, Ailawadi G, Lim DS, Blanke P, Eleid MF, Kaneko T, Thourani VH, Bapat V, Mack MJ, Leon MB, George I. Diagnosis, Classification, and Management Strategies for Mitral Annular Calcification: A Heart Valve Collaboratory Position Statement. JACC Cardiovasc Interv. 2023 Sep 25;16(18):2195-2210. doi: 10.1016/j.jcin.2023.06.044. PMID: 37758378.
- Simpson MT, Kachel M, Mirza F, Shea NJ, Takeda K, Takayama H, George I. Anatomic considerations after commando double valve reconstruction: insights for future valve-in-valve therapies. Eur J Cardiothorac Surg. 2023 Aug 1;64(2):ezad155. doi: 10.1093/ejcts/ezad155. PMID: 37067485.
- Lawlor MK, Hamid N, Kampaktsis P, Ning Y, Wang V, Akkoc D, Dershowitz L, Placheril E, Vahl TP, Nazif T, Khalique O, Ng V, Brener MI, Burkhoff D, Dickstein M, Kurlansky P, Leon MB, Hahn RT, Kodali S, George I. Incidence and predictors of cardiogenic shock following surgical or transcatheter tricuspid valve intervention. Catheter Cardiovasc Interv. 2022 Apr;99(5):1668-1678. doi: 10.1002/ccd.30073. Epub 2022 Jan 23. PMID: 35066989.
- Nazif TM, Cahill TJ, Daniels D, McCabe JM, Reisman M, Chakravarty T, Makkar R, Krishnaswamy A, Kapadia S, Chehab BM, Wang J, Spies C, Rodriguez E, Kaneko T, Hahn RT, Leon MB, George I. Real-World Experience With the SAPIEN 3 Ultra Transcatheter Heart Valve: A Propensity-Matched Analysis From the United States. Circ Cardiovasc Interv. 2021 Sep;14(9):e010543. doi: 10.1161/CIRCINTERVENTIONS.121.010543. Epub 2021 Aug 26. PMID: 34433290.
- Kalfa DM, Buratto E, Bacha EA, Belli E, Barron DJ, Ly M, Nield L, McLeod C, Khairy P, Babu-Narayan SV, Kowalik E, Elder RW, Baruteau AE; DISCO Consortium. Single ventricle palliation in congenitally corrected transposition of the great arteries: An international multicenter study. J Thorac Cardiovasc Surg. 2024 Sep 14:S0022-5223(24)00805-5. doi: 10.1016/j.jtcvs.2024.08.051. Epub ahead of print. PMID: 39278615.
- Kalfa D, Karamichalis JM, Singh SK, Jiang P, Anderson BR, Vargas D, Choudhury T, Habib A, Bacha E. Operative mortality after Society of Thoracic Surgeons-European Association for Cardio-Thoracic Surgery Mortality Category 1 to 3 procedures: Deficiencies and opportunities for quality improvement. J Thorac Cardiovasc Surg. 2023 Aug;166(2):325-333.e3. doi: 10.1016/j.jtcvs.2022.11.022. Epub 2022 Nov 30. PMID: 36621456.
- Kalfa D, Richmond M, Cordoves E, Lee T, Zuckerman W, Jurgensen S, Shah A, Bacha E, Goldstone A.. Domino heart valve transplant in children with congenital valve disease: short-term outcomes, growth potential and immunosensitization, JACC, 2024
- Cordoves EM, Ferrari G, Zorn E, Bacha E, Vunjak-Novakovic G, Kalfa DM. Storage, preservation, and rehabilitation of living heart valves to treat congenital heart disease. Med. 2024 Aug 9;5(8):859-862. doi: 10.1016/j.medj.2024.07.004. PMID: 39127035.
- Writing Committee Members; Lawton JS, Tamis-Holland JE, Bangalore S, Bates ER, Beckie TM, Bischoff JM, Bittl JA, Cohen MG, DiMaio JM, Don CW, Fremes SE, Gaudino MF, Goldberger ZD, Grant MC, Jaswal JB, Kurlansky PA, Mehran R, Metkus TS Jr, Nnacheta LC, Rao SV, Sellke FW, Sharma G, Yong CM, Zwischenberger BA. 2021 ACC/AHA/SCAI Guideline for Coronary Artery Revascularization: A Report of the American College of Cardiology/American Heart Association Joint Committee on Clinical Practice Guidelines. J Am Coll Cardiol. 2022 Jan 18;79(2):e21-e129. doi: 10.1016/j.jacc.2021.09.006. Epub 2021 Dec 9. Erratum in: J Am Coll Cardiol. 2022 Apr 19;79(15):1547. doi: 10.1016/j.jacc.2022.03.330. Erratum in: J Am Coll Cardiol. 2024 Aug 20;84(8):771. doi: 10.1016/j.jacc.2024.07.010. PMID: 34895950.
- Kurlansky PA, Traad EA, Ebra G. Mitral Repair vs Replacement for Degenerative Mitral Regurgitation in Patients Aged ≥65 Years. Ann Thorac Surg. 2023 Oct;116(4):736-742. doi: 10.1016/j.athoracsur.2023.05.023. Epub 2023 Jun 10. PMID: 37308067.
- Kurlansky PA, O'Brien SM, Vassileva CM, Lobdell KW, Edwards FH, Jacobs JP, Wyler von Ballmoos M, Paone G, Edgerton JR, Thourani VH, Furnary AP, Ferraris VA, Cleveland JC Jr, Bowdish ME, Likosky DS, Badhwar V, Shahian DM. Failure to Rescue: A New Society of Thoracic Surgeons Quality Metric for Cardiac Surgery. Ann Thorac Surg. 2022 Jun;113(6):1935-1942. doi: 10.1016/j.athoracsur.2021.06.025. Epub 2021 Jul 6. PMID: 34242640.
- Gaudino M, Bakaeen FG, Sandner S, Aldea GS, Arai H, Chikwe J, Firestone S, Fremes SE, Gomes WJ, Bong-Kim K, Kisson K, Kurlansky P, Lawton J, Navia D, Puskas JD, Ruel M, Sabik JF, Schwann TA, Taggart DP, Tatoulis J, Wyler von Ballmoos M. Expert systematic review on the choice of conduits for coronary artery bypass grafting: endorsed by the European Association for Cardio-Thoracic Surgery (EACTS) and The Society of Thoracic Surgeons (STS). J Thorac Cardiovasc Surg. 2023 Oct;166(4):1099-1114. doi: 10.1016/j.jtcvs.2023.06.017. Epub 2023 Aug 3. PMID: 37542480.
- Jacobs JP, Shahian DM, Grau-Sepulveda M, O'Brien SM, Pruitt EY, Bloom JP, Edgerton JR, Kurlansky PA, Habib RH, Antman MS, Cleveland JC Jr, Fernandez FG, Thourani VH, Badhwar V. Current Penetration, Completeness, and Representativeness of The Society of Thoracic Surgeons Adult Cardiac Surgery Database. Ann Thorac Surg. 2022 May;113(5):1461-1468. doi: 10.1016/j.athoracsur.2021.04.107. Epub 2021 Jun 18. PMID: 34153294.
- Bacha E. Mentoring Pediatric Heart Surgeons: A Difficult Road for Both Mentors and Mentees. World J Pediatr Congenit Heart Surg. 2024 Jul;15(4):494-497. doi: 10.1177/21501351241247525. Epub 2024 May 23. PMID: 38780435.
- Nguyen SN, Chung MM, Vinogradsky AV, Richmond ME, Zuckerman WA, Goldstone AB, Bacha EA. Long-term outcomes of surgery for obstructive hypertrophic cardiomyopathy in a pediatric cohort. JTCVS Open. 2023 Oct 4;16:726-738. doi: 10.1016/j.xjon.2023.09.032. PMID: 38204697; PMCID: PMC10775098.
- Bacha EA, Nguyen SN, Vanderlaan R, LaPar DJ, Goldstone AB, Kalfa DM. Aortic root translocation (Nikaidoh) procedure for complex transposition of the great arteries with left ventricular outflow tract obstruction. JTCVS Tech. 2023 Oct 18;22:243-250. doi: 10.1016/j.xjtc.2023.10.006. PMID: 38152235; PMCID: PMC10750979.
- Boyd R, Kalfa D, Nguyen S, Setton M, Shah A, Karamichalis J, Lewis M, Wassercug NZ, Rosenbaum M, Bacha E. Comparative outcomes and risk analysis after cone repair or tricuspid valve replacement for Ebstein's anomaly. JTCVS Open. 2023 Mar 17;14:372-384. doi: 10.1016/j.xjon.2023.03.004. PMID: 37425446; PMCID: PMC10328840.
- Hayashi H, Kirschner M, Vinogradsky A, Ning Y, Kurlansky P, Yuzefpolskaya M, Colombo PC, Sayer GT, Uriel N, Naka Y, Takeda K. Acute right ventricular geometric change predicts outcomes in HeartMate 3 patients. J Heart Lung Transplant. 2024 Apr;43(4):642-651. doi: 10.1016/j.healun.2023.11.020. Epub 2023 Dec 7. PMID: 38070663.
- Vinogradsky A, Ning Y, Kurlansky P, Kirschner M, Yuzefpolskaya M, Colombo P, Sayer G, Uriel N, Naka Y, Takeda K. Less is better? Comparing effects of median sternotomy and thoracotomy surgical approaches for left ventricular assist device implantation on postoperative outcomes and valvulopathy. J Thorac Cardiovasc Surg. 2024 Feb;167(2):731-743.e3. doi: 10.1016/j.jtcvs.2022.04.036. Epub 2022 May 17. PMID: 36008179; PMCID: PMC9669283.
- Mehra MR, Netuka I, Uriel N, Katz JN, Pagani FD, Jorde UP, Gustafsson F, Connors JM, Ivak P, Cowger J, Ransom J, Bansal A, Takeda K, Agarwal R, Byku M, Givertz MM, Bitar A, Hall S, Zimpfer D, Vega JD, Kanwar MK, Saeed O, Goldstein DJ, Cogswell R, Sheikh FH, Danter M, Pya Y, Phancao A, Henderson J, Crandall DL, Sundareswaran K, Soltesz E, Estep JD; ARIES-HM3 Investigators. Aspirin and Hemocompatibility Events With a Left Ventricular Assist Device in Advanced Heart Failure: The ARIES-HM3 Randomized Clinical Trial. JAMA. 2023 Dec 12;330(22):2171-2181. doi: 10.1001/jama.2023.23204. PMID: 37950897; PMCID: PMC10640705.
- Vidula H, Takeda K, Estep JD, Silvestry SC, Milano C, Cleveland JC Jr, Goldstein DJ, Uriel N, Kormos RL, Dirckx N, Mehra MR. Hospitalization Patterns and Impact of a Magnetically-Levitated Left Ventricular Assist Device in the MOMENTUM 3 Trial. JACC Heart Fail. 2022 Jul;10(7):470-481. doi: 10.1016/j.jchf.2022.03.007. Epub 2022 Jun 8. PMID: 35772857.
- Kaneko T, Hirji S, Zaid S, Lange R, Kempfert J, Conradi L, Hagl C, Borger MA, Taramasso M, Nguyen TC, Ailawadi G, Shah AS, Smith RL, Anselmi A, Romano MA, Ben Ali W, Ramlawi B, Grubb KJ, Robinson NB, Pirelli L, Chu MWA, Andreas M, Obadia JF, Gennari M, Garatti A, Tchetche D, Nazif TM, Bapat VN, Modine T, Denti P, Tang GHL; CUTTING-EDGE Investigators. Mitral Valve Surgery After Transcatheter Edge-to-Edge Repair: Mid-Term Outcomes From the CUTTING-EDGE International Registry. JACC Cardiovasc Interv. 2021 Sep 27;14(18):2010-2021. doi: 10.1016/j.jcin.2021.07.029. PMID: 34556275.
- Kaneko T, Bapat VN, Alakhtar AM, Zaid S, George I, Grubb KJ, Harrington K, Pirelli L, Atkins M, Desai ND, Bleiziffer S, Noack T, Modine T, Denti P, Kempfert J, Ruge H, Vitanova K, Falk V, Thourani VH, Bavaria JE, Reardon MJ, Mack MJ, Borger MA, Leon MB, Tang GHL, Fukuhara S. Transcatheter heart valve explantation for transcatheter aortic valve replacement failure: A Heart Valve Collaboratory expert consensus document on operative techniques. J Thorac Cardiovasc Surg. 2024 Apr 25:S0022-5223(24)00369-6. doi: 10.1016/j.jtcvs.2024.04.025. Epub ahead of print. PMID: 38677492.
- Tang GHL, Zaid S, Kleiman NS, Goel SS, Fukuhara S, Marin-Cuartas M, Kiefer P, Abdel-Wahab M, De Backer O, Søndergaard L, Saha S, Hagl C, Wyler von Ballmoos M, Bhadra O, Conradi L, Grubb KJ, Shih E, DiMaio JM, Szerlip M, Vitanova K, Ruge H, Unbehaun A, Kempfert J, Pirelli L, Kliger CA, Van Mieghem N, Hokken TW, Adrichem R, Modine T, Corona S, Wang L, Petrossian G, Robinson N, Meier D, Webb JG, Cheung A, Ramlawi B, Herrmann HC, Desai ND, Andreas M, Mach M, Waksman R, Schults CC, Ahmad H, Goldberg JB, Geirsson A, Forrest JK, Denti P, Belluschi I, Ben-Ali W, Asgar AW, Taramasso M, Rovin JD, Di Eusanio M, Colli A, Kaneko T, Nazif TN, Leon MB, Bapat VN, Mack MJ, Reardon MJ, Sathananthan J. Explant vs Redo-TAVR After Transcatheter Valve Failure: Mid-Term Outcomes From the EXPLANTORREDO-TAVR International Registry. JACC Cardiovasc Interv. 2023 Apr 24;16(8):927-941. doi: 10.1016/j.jcin.2023.01.376. PMID: 37100556.
- Xue Y, Kossar AP, Abramov A, Frasca A, Sun M, Zyablitskaya M, Paik D, Kalfa D, Della Barbera M, Thiene G, Kozaki S, Kawashima T, Gorman JH, Gorman RC, Gillespie MJ, Carreon CK, Sanders SP, Levy RJ, Ferrari G. Age-related enhanced degeneration of bioprosthetic valves due to leaflet calcification, tissue crosslinking, and structural changes. Cardiovasc Res. 2023 Mar 17;119(1):302-315. doi: 10.1093/cvr/cvac002. PMID: 35020813; PMCID: PMC10022861.
- Castillero E, Fitzpatrick E, Keeney SJ, D'Angelo AM, Pressly BB, Simpson MT, Kurade M, Erwin WC, Moreno V, Camillo C, Shukla HJ, Inamdar VV, Aghali A, Grau JB, Salvati E, Nissim I, Rauova L, Oyama MA, Stachelek SJ, Brown C, Krieger AM, Levy RJ, Ferrari G. Decreased serotonin transporter activity in the mitral valve contributes to progression of degenerative mitral regurgitation. Sci Transl Med. 2023 Jan 4;15(677):eadc9606. doi: 10.1126/scitranslmed.adc9606. Epub 2023 Jan 4. PMID: 36599005; PMCID: PMC9896655.
- Abramov A, Xue Y, Zakharchenko A, Kurade M, Soni RK, Levy RJ, Ferrari G. Bioprosthetic heart valve structural degeneration associated with metabolic syndrome: Mitigation with polyoxazoline modification. Proc Natl Acad Sci U S A. 2023 Jan 3;120(1):e2219054120. doi: 10.1073/pnas.2219054120. Epub 2022 Dec 27. PMID: 36574676; PMCID: PMC9910464.
- Castillero E, Howsmon DP, Rego BV, Keeney SJ, Driesbaugh KH, Kawashima T, Xue Y, Camillo C, George I, Gorman RC, Gorman JH 3rd, Sacks MS, Levy RJ, Ferrari G. Altered Responsiveness to TGFβ and BMP and Increased CD45+ Cell Presence in Mitral Valves Are Unique Features of Ischemic Mitral Regurgitation. Arterioscler Thromb Vasc Biol. 2021 Jun;41(6):2049-2062. doi: 10.1161/ATVBAHA.121.316111. Epub 2021 Apr 8. PMID: 33827255; PMCID: PMC8159877.
- Frasca A, Xue Y, Kossar AP, Keeney S, Rock C, Zakharchenko A, Streeter M, Gorman RC, Grau JB, George I, Bavaria JE, Krieger A, Spiegel DA, Levy RJ, Ferrari G. Glycation and Serum Albumin Infiltration Contribute to the Structural Degeneration of Bioprosthetic Heart Valves. JACC Basic Transl Sci. 2020 Aug 5;5(8):755-766. doi: 10.1016/j.jacbts.2020.06.008. PMID: 32875167; PMCID: PMC7452200.
- Kochar A, Zheng Y, van Diepen S, Mehta RH, Westerhout CM, Mazer DC, Duncan AI, Whitlock R, Lopes RD, Argenziano M, de Varennes B, Alexander JH, Goodman SG, Fremes S. Predictors and associated clinical outcomes of low cardiac output syndrome following cardiac surgery: insights from the LEVO-CTS trial. Eur Heart J Acute Cardiovasc Care. 2022 Nov 30;11(11):818-825. doi: 10.1093/ehjacc/zuac114. PMID: 36156131.
- George I, Salna M, Kobsa S, Deroo S, Kriegel J, Blitzer D, Shea NJ, D'Angelo A, Raza T, Kurlansky P, Takeda K, Takayama H, Bapat V, Naka Y, Smith CR, Bacha E, Argenziano M. The rapid transformation of cardiac surgery practice in the coronavirus disease 2019 (COVID-19) pandemic: Insights and clinical strategies from a center at the epicenter. J Thorac Cardiovasc Surg. 2020 Oct;160(4):937-947.e2. doi: 10.1016/j.jtcvs.2020.04.060. Epub 2020 Jul 2. PMID: 32624303; PMCID: PMC7331531.
- Argenziano M, Fischkoff K, Smith CR. Surgery Scheduling in a Crisis. N Engl J Med. 2020 Jun 4;382(23):e87. doi: 10.1056/NEJMc2017424. Epub 2020 May 22. PMID: 32445439; PMCID: PMC7262972.
- DeRose JJ Jr, Mancini DM, Chang HL, Argenziano M, Dagenais F, Ailawadi G, Perrault LP, Parides MK, Taddei-Peters WC, Mack MJ, Glower DD, Yerokun BA, Atluri P, Mullen JC, Puskas JD, O'Sullivan K, Sledz NM, Tremblay H, Moquete E, Ferket BS, Moskowitz AJ, Iribarne A, Gelijns AC, O'Gara PT, Blackstone EH, Gillinov AM; CTSN Investigators. Pacemaker Implantation After Mitral Valve Surgery With Atrial Fibrillation Ablation. J Am Coll Cardiol. 2019 May 21;73(19):2427-2435. doi: 10.1016/j.jacc.2019.02.062. PMID: 31097163; PMCID: PMC6602091.
- Blitzer D, Benintende AJ, Nemeth S, Kurlansky P, Antkowiak M, Fischkoff K, Argenziano M, Takayama H. Trends in Comprehensive Thoracic Case Experience Among General Surgery Residents in the Modern Integrated Cardiothoracic Residency Era: Review of Twenty Years of Resident Case Logs. Am Surg. 2023 Dec;89(12):5512-5519. doi: 10.1177/00031348231157417. Epub 2023 Feb 16. PMID: 36797046.
Our Team
Surgical CVRI members are scientists and surgeon scientists within the Department of Surgery who are engaged in NIH-supported research activities across a broad spectrum of research areas.
Leadership
Leadership of the CVRI consists of experts and leaders in translational research within the field of cardiovascular disease and surgery. The organization consists of co-directors, advisory council, and administrative support.






Amanda Alonzo, Admin
Colina Williams, Admin
Faculty

Stories & Perspectives
Columbia Surgical Cardiovascular Research Institute (CVRI) Aims to Advance the Field of Cardiovascular Surgery
The Columbia Surgical Cardiovascular Research Institute serves as resource and support system for researchers and physician-scientists across Columbia
Education and Training
The Surgical CVRI is committed to improving cardiovascular research by offering continuing education programs and training opportunities.
Join Our Team
Opportunities to join CVRI currently include:
- Research associates
- Open position for surgical residents interested in 1-2 year research projects with CVRI faculty
Please fill out our contact form to learn more.
Support the Surgical CVRI
Your generous contribution can help CVRI fulfill our mission of supporting cardiovascular surgery research to improve today’s treatments and develop tomorrow's breakthroughs.